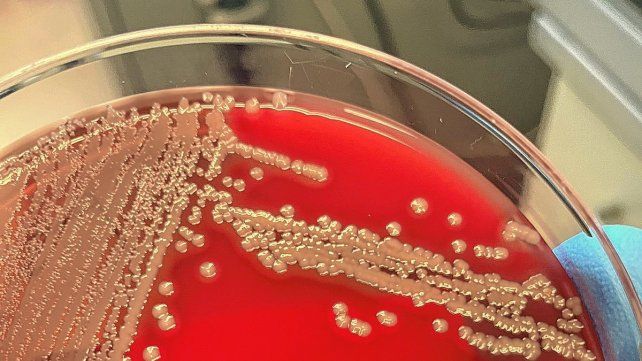

El Ministerio de Salud informó este sábado que se notificaron 118 casos confirmados de infección invasiva por Streptococcus pyogenes en Argentina, una bacteria Gram-positiva que es la causa bacteriana más frecuente de faringitis aguda e infecciones cutáneas como impétigo, celulitis y escarlatina, de los cuales 16 de ellos fallecieron.
Notificaron 118 casos de Streptococcus Pyogenes en el país y ya son 16 los fallecidos por infección masiva
En relación con los casos confirmados de infección invasiva por Streptococcus pyogenes en los años anteriores (2019-2022), el mayor número de casos se había registrado en 2022 (año cerrado) con 75 casos reportados; por lo que el número de 2023 representa un aumento del 281% respecto al mismo período de 2019, informó Télam.
Esto sucede en el contexto internacional en el cual el 8 de diciembre de 2022 la Organización Mundial de la Salud (OMS) informó que al menos cinco Estados miembros de la región europea (Francia, Irlanda, los Países Bajos, Suecia y el Reino Unido de Gran Bretaña e Irlanda del Norte) habían reportado un aumento en el número de casos de enfermedad invasiva por estreptococo del grupo A (Streptococcus pyogenes) y el 19 de diciembre de 2022 la Organización Panamericana de la Salud (OPS) también emitió un comunicado debido a un aumento de casos registrado en Uruguay.
Streptococcus pyogenes, una infección invasiva
El Streptococcus pyogenes, también conocido como Streptococcus grupo A, en general causa enfermedades leves como amigdalitis, faringitis, impétigo, celulitis y escarlatina. Sin embargo, en raras ocasiones, la infección puede conducir a la enfermedad invasiva que puede provocar condiciones potencialmente mortales, siendo responsable de más de 500.000 muertes anuales en todo el mundo.
La transmisión ocurre por contacto cercano con una persona infectada y puede transmitirse a través de la tos, los estornudos o el contacto con una herida. El período de incubación para la enfermedad varía, de acuerdo a la presentación clínica, entre 1 a 3 días. El tratamiento de las personas infectadas con antibiótico durante por lo menos 24 horas elimina por lo general su capacidad de propagación.
La faringitis se diagnostica mediante cultivos bacterianos y se trata con antibióticos. La higiene de las manos y la higiene personal pueden ayudar a controlar la transmisión.
Los síntomas de la faringitis son dolor de garganta; fiebre; cefaleas; dolor abdominal; náuseas y vómitos; enrojecimiento de faringe y amígdalas; mal aliento; ganglios aumentados de tamaño en el cuello.
En lo referido a la escarlatina, los síntomas más frecuentes son garganta roja y adolorida; fiebre (38.3 °C o más); erupción color rojo con textura de papel de lija; piel de color rojo intenso en los pliegues de axila, codo e ingle; recubrimiento blancuzco sobre la lengua o el fondo de la garganta; lengua "aframbuesada"; dolor de cabeza; náuseas o vómitos; inflamación de los ganglios; dolores en el cuerpo.
Ante la presencia de algunos de estos síntomas es importante evitar la automedicación con antibióticos y realizar una consulta médica para tener diagnóstico oportuno. En el caso de recibir indicación médica de tratamiento antibiótico, es fundamental completar el esquema (no acortar ni abandonar los tratamientos anticipadamente), ya que la utilización inadecuada de los antibióticos promueve la resistencia bacteriana, hecho que atenta contra su efectividad en el futuro.
Las personas enfermas deben evitar concurrir a lugares públicos (trabajo, escuela) y restringir los contactos hogareños. Además es de importancia lavarse las manos frecuentemente; no compartir objetos de uso personal (cubiertos, vasos, toallas, entre otros) y ventilar adecuadamente y de forma regular los ambientes. Por último, la cartera sanitaria nacional recuerda adicionalmente que todas las personas deben tener al día la vacunación antigripal y contra Coronavirus, muy especialmente aquellas que presentan factores de riesgo.